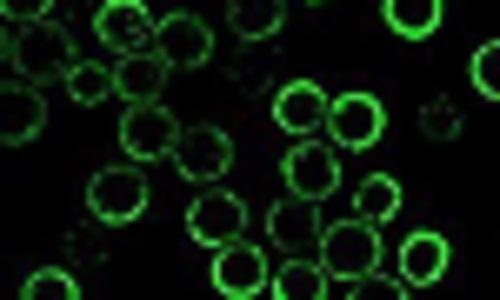

Press release
Protein Expression Market 2019 By Key Players ABNOVA (TAIWAN) CORP. ACCELAGEN INC. AGILENT TECHNOLOGIES INC. BIO-RAD LABORATORIES INC. BIOMATIK DOMAINEX LTD. ENZO LIFE SCIENCES INC. EXON BIOSYSTEMS GENSCRIPT LONZA GROUP AG LUCIGEN CORP. MERCK KGAA NEW ENG
SummaryProtein expression is a technique where three processes—translation, transcription and posttranslational modification—play a vital role in the various applications, including biologics production, therapeutic protein production and research application. There are three types of recombinant protein expression methods. These include in vivo protein expression, in vitro protein expression and chemical protein synthesis. It is critical to have access to a variety of expression tools to ensure the successful expression of the required target protein.
Request a Sample of this Report @ https://www.orbisresearch.com/contacts/request-sample/2676893
Based on the functional need in the host cell, proteins can be modified, regulated and synthesized in different living organisms. These proteins need a specific intracellular environment to achieve the required secondary and tertiary structures. Some proteins also require post-translational modifications or insertion into a cellular membrane to attain the proper functioning of the protein. In addition, the production of some proteins could also be toxic for the well-being of the host. Hence, there is no single solution for the successful production of different types of recombinant proteins.
In this report, the protein expression market is studied through different perspectives. The market is analyzed through the products and their applications in the treatment of several chronic diseases. The protein expression market is categorized into six types based on system type: prokaryotic expression system, mammalian cell expression system, insect cell expression system, yeast cell expression system, cell-free expression system and algal-based expression system. The prokaryotic expression system registered a revenue of REDACTED in 2016 and is poised to increase at a compound annual growth rate (CAGR) of REDACTED throughout the forecast period. Its revenue is projected to reach REDACTED by 2022.
Browse the Full Report @ https://www.orbisresearch.com/reports/index/protein-expression-global-markets
The global market for protein expression based on products and services is segmented into five categories: reagents, expression vectors, competent cells, instruments and services. The reagents segment has dominated the global market for protein expression and is anticipated to do so during the forecast period. This segment accounted for a revenue of REDACTED in 2016, registering a CAGR of REDACTED; this revenue is expected to reach nearly REDACTED by 2022.
By geography, the global market for protein expression is divided into North America, Europe, Asia-Pacific and the Rest of World (ROW). North America held the largest market share in 2016 and accounted for REDACTED, growing at the CAGR of REDACTED during the analysis period. It is anticipated that market will reach nearly REDACTED by 2022. Europe held the second-largest market share of the protein expression market globally. It accounted for REDACTED in 2016 and is expected to reach REDACTED by 2022 at a CAGR of REDACTED. The Asia-Pacific market accounted for REDACTED in 2016 and is expected to reach REDACTED by 2022 at a CAGR of REDACTED. ROW includes Brazil, Saudi Arabia, and South Africa. The ROW protein expression market accounted for REDACTED in 2016 and is expected to reach REDACTED by 2022 at a CAGR of REDACTED.
Report Scope:
This research report presents an in-depth analysis of the global market for protein expression by system type, products and services, applications, end users and regional markets. The report includes key protein expression systems that are incorporated in several therapeutic treatment methods. It discusses the role of supply chain members from manufacturers to researchers. The report provides an in-depth analysis of key companies operating in the global market for protein expression. A patent analysis focuses on describing technological trends across periods of time and regions, such as the U.S., Europe and Japan.
The protein expression market is mainly segmented into the following system types: prokaryotic expression systems, mammalian cell expression systems, insect cell expression systems, yeast expression systems, cell-free expression systems and algal-based expression systems. This market is further segmented based on products and services into reagents, expression vectors, competent cells, instruments and services. The market study details end users and applications, and ongoing activity in the research and development area. The market is segmented by region into North America, Europe, Asia-Pacific and the rest of the world (ROW). Companies profiled in this report include Thermo Fisher Scientific Inc., Merck KGaA, Promega Corp., Agilent Technologies, GenScript, Takara Holdings Inc., Bio-Rad Laboratories Inc., Qiagen N.V., Lonza and others.
Make an enquiry before buying this report @ https://www.orbisresearch.com/contacts/enquiry-before-buying/2676893
Report Includes:
- 45 data tables 34 additional tables
- An overview and in-depth analysis of the global markets for protein expression technologies
- Analyses of global market trends with data from 2016 and 2017, and projections of compound annual growth rates (CAGRs) through 2022
- Discussion on perfusion approaches and supporting practices such as continuous bio manufacturing, and digital and model-based controls
- Identification of key market dynamics and the factors impacting the global market for protein expression and its sub-segments
- Regional dynamics of the global protein expression market and analysis of trends and opportunities in major regions covering North America, Europe, Asia-Pacific and the rest of the world (ROW)
- A relevant patent analysis focuses on describing technological trends across periods of time and regions, such as the U.S., Europe and Japan
- Detailed analysis of the cloning technologies, production of recombinant proteins and problems associated with protein production
- Assessment of major stakeholders, product portfolios and recent developments and the competitive landscape among market leaders
- Company profiles of leading global payers, including Agilent Technologies, Bio-Rad Laboratories Inc., Merck KGaA, Promega Corp., GenScript, Thermo Fisher Scientific Inc., and Qiagen N.V.
Companies Mentioned:
ABNOVA (TAIWAN) CORP.
ACCELAGEN INC.
AGILENT TECHNOLOGIES INC.
BIO-RAD LABORATORIES INC.
BIOMATIK
DOMAINEX LTD.
ENZO LIFE SCIENCES INC.
EXON BIOSYSTEMS
GENSCRIPT
LONZA GROUP AG
LUCIGEN CORP.
MERCK KGAA
NEW ENGLAND BIOLABS INC.
NOVOPROTEIN SCIENTIFIC INC.
ORIGENE TECHNOLOGIES INC.
OXFORD EXPRESSION TECHNOLOGIES LTD.
PROMEGA CORP.
PROTEOGENIX INC.
QIAGEN INC.
R&D SYSTEMS INC.
SINO BIOLOGICAL INC.
SYNGENE
SYNTHETIC GENOMICS INC.
TAKARA HOLDINGS, INC.
Orbis Research (orbisresearch.com) is a single point aid for all your market research requirements. We have vast database of reports from the leading publishers and authors across the globe. We specialize in delivering customized reports as per the requirements of our clients. We have complete information about our publishers and hence are sure about the accuracy of the industries and verticals of their specialization. This helps our clients to map their needs and we produce the perfect required market research study for our clients.
Hector Costello
Senior Manager – Client Engagements
4144N Central Expressway,
Suite 600, Dallas,
Texas - 75204, U.S.A.
Phone No.: +1 (214) 884-6817; +912064101019
This release was published on openPR.
Permanent link to this press release:
Copy
Please set a link in the press area of your homepage to this press release on openPR. openPR disclaims liability for any content contained in this release.
You can edit or delete your press release Protein Expression Market 2019 By Key Players ABNOVA (TAIWAN) CORP. ACCELAGEN INC. AGILENT TECHNOLOGIES INC. BIO-RAD LABORATORIES INC. BIOMATIK DOMAINEX LTD. ENZO LIFE SCIENCES INC. EXON BIOSYSTEMS GENSCRIPT LONZA GROUP AG LUCIGEN CORP. MERCK KGAA NEW ENG here
News-ID: 1588740 • Views: …
More Releases from Orbis Research
Blood Purification Devices Market 2023-2028 | Top Players Baxter International, …
Based on the type segment, the portable equipment segment is expected to hold the largest share in Blood Purification Devices in the year 2028. Professionals that are actively involved in the ongoing purification of blood tend to favour portable equipment. Equipment that is portable enables effective emergency care. Additionally, portable equipment is rather space-efficient and compact, which promotes widespread use throughout the blood-purification process. In a manner similar to how…
Clean Beauty Market to Grow at 40.1% CAGR by 2028 - Key Players are Bare Mineral …
Clean beauty is described as beauty and personal care products that are made with the safest possible ingredients and have the lowest possible environmental impacts. Clean beauty pertains to products that are safe, non-toxic, and clearly labelled ingredients Also, the ingredients used are cruelty-free and are screened for non-GMO feedstock and residual pesticides.
Request a pdf brochure @ https://www.orbisresearch.com/contacts/request-sample/6941781
The Clean Beauty Market is valued at USD 5163.17 Million in 2021 and…
Outdoor Power Equipment Market Worth USD 6.49 Bn by 2027 - Industry Trends and S …
The outdoor power equipment generally includes, brush cutters, edger, chain saws, power rakes, and more. Outdoor power equipment is commonly used by end users, such as lawn & plant care providers and landscape service providers, for commercial purposes.
The global outdoor power equipment market in 2021 was valued at US$32.22 billion. The market value is projected to reach US$46.49 billion by 2027. Outdoor power equipment (OPE) is an equipment with small…
Merchant API Market to reach US$119.11 billion by 2027 - Industry Trends, Growth …
The latest research on "Global Merchant API Market: Analysis By Molecular Type, By Segment, By Type, By Type of Synthesis, By End-User, By Region Size And Trends With Impact Of COVID-19 And Forecast up to 2027" have been added to OrbisResearch.com store.
The merchant API market refers to the use of APIs by merchants, or businesses that sell goods and services, to connect their systems and processes with those of other…
More Releases for REDACTED
Nanotechnology in Energy Applications Market To 2023 - Altair Nanotechnologies, …
Albany, NY, 14th June : Recent research and the current scenario as well as future market potential of "Nanotechnology in Energy Applications" globally.
This report describes the market for nanoscale materials and devices used in current and future generations of energy devices and systems. The focus is on nanotechnology applications that are in commercial use today or are likely to be commercialized by 2023.
Get Free PDF for more Professional and Technical…
Worldwide Technology : Gas Engines for Drones and Electric Vehicles Market to 20 …
Albany, NY, 22nd February : Recent research and the current scenario as well as future market potential of "Gas Engines for Drones and Electric Vehicles: Global Markets Through 2023" globally.
Summary
The internal combustion engine, the most common engine used in commercial and consumer vehicles, is a study in contrasts when it comes to environmental considerations. On the one hand, there is pressure to discontinue or reduce use of these gas-powered engines…
Gas Engines for Drones and Electric Vehicles Market Trends and Forecast 2025 : B …
ResearchMoz include new market research report "Gas Engines for Drones and Electric Vehicles: Global Markets Through 2023" to its huge collection of research reports.
The internal combustion engine, the most common engine used in commercial and consumer vehicles, is a study in contrasts when it comes to environmental considerations. On the one hand, there is pressure to discontinue or reduce use of these gas-powered engines because of CO2 emissions. On the…
Gas Engines for Drones and Electric Vehicles: Global Markets Through 2023 : BAIC …
Researchmoz added Most up-to-date research on "Gas Engines for Drones and Electric Vehicles: Global Markets Through 2023" to its huge collection of research reports.
"Summary
The internal combustion engine, the most common engine used in commercial and consumer vehicles, is a study in contrasts when it comes to environmental considerations. On the one hand, there is pressure to discontinue or reduce use of these gas-powered engines because of CO2 emissions. On…
Polyamides Market is expected to increase at a compound annual growth rate (CAGR …
Researchmoz added Most up-to-date research on "Polyamides: Types and Global Markets" to its huge collection of research reports.
"Summary
Polyamides are characterized by amide groups (CONH) and include a range of types such as PA66, PA4/6, PA6, PA6/12, PA12 and others. It is used in the manufacture of fiber and film and is also available as a molding compound. Polyamides are the biggest family of engineering plastics, with a wide range of…
Solar Electric Power Generation growth rate (CAGR) of REDACTED% to nearly $REDAC …
Researchmoz added Most up-to-date research on "Solar Electric Power Generation: Global Markets to 2023" to its huge collection of research reports.
"Summary
The solar electric power generation market growth outlook is stable with significant growth potential for electricity from residential customers. There is mounting pressure to reduce costs, improve power supply and improve efficiency of solar generation. At the same time, factors such as emerging market growth, rapid urbanization and industrialization are…